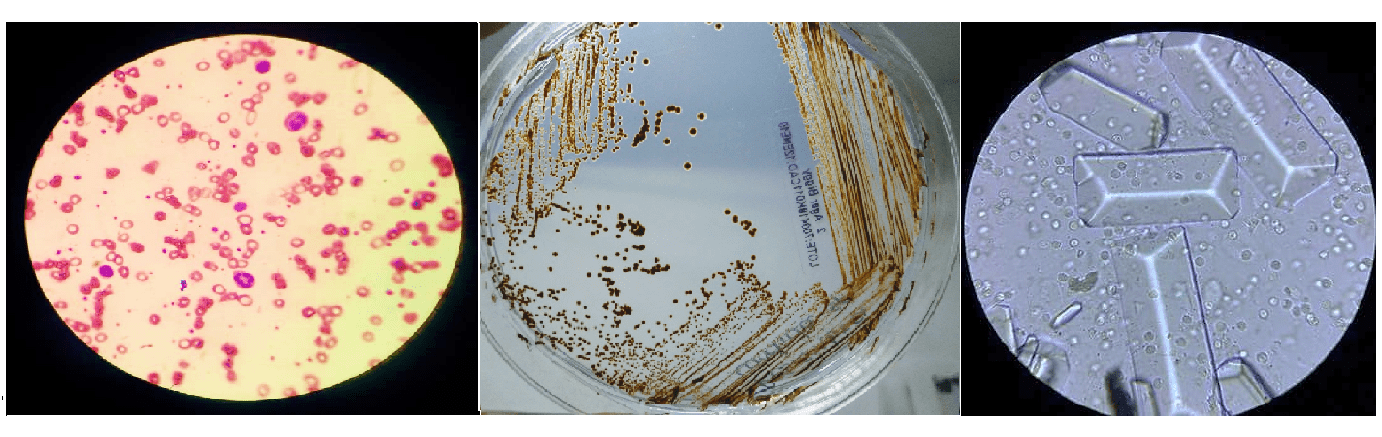

DENGUE - Sabías qué...?

OFERTAS DEL MES
– QUÍMICA SANGUÍNEA DE 6 ELEMENTOS POR SOLO $480.00 – PERFIL DE LÍPIDOS POR SOLO $480.00 – ANTÍGENO RÁPIDO DE COVID POR SOLO $280.00

PERFIL CONTROL DIABÉTICO ESPECIAL
– Biometría Hemática – Hemoglobina Glicosilada A1c – Examen General de Orina – Química sanguínea de 6 elementos – Microalbúmina en Orina Ocasional POR SOLO $510.00 31 de MARZO DEL 2026 O HASTA AGOTAR EXISTENCIAS. Precios sujetos a cambios sin

CHECK UP PROMOCIÓN I
– QUÍMICA SANGUÍNEA DE 24 ELEMENTOS – BIOMETRÍA HEMÁTICA – EXÁMEN GENERAL DE ORINA POR SOLO $695.00 Promoción valida 31 de MARZO DEL 2026 O HASTA AGOTAR EXISTENCIAS.

CHECK UP PROMOCIÓN II
– QUÍMICA SANGUÍNEA DE 33 ELEMENTOS – BIOMETRÍA HEMÁTICA – EXAMEN GENERAL DE ORINA POR SOLO $850.00 Promoción valida 31 de MARZO DEL 2026 O HASTA AGOTAR EXISTENCIAS.

CHECK UP FEMENINO PROMOCIÓN
– PAPANICOLAOU – CULTIVO VAGINAL – EXAMEN GENERAL DE ORINA POR SOLO $990.00 Promoción valida 31 de MARZO DEL 2026 O HASTA AGOTAR EXISTENCIAS. **SE REQUIERE PREVIA CITA

CHECK UP MASCULINO PROMOCIÓN
– QUÍMICA SANGUÍNEA DE 33 ELEMENTOS – BIOMETRÍA HEMÁTICA – EXAMEN GENERAL DE ORINA – ANTÍGENO ESPECÍFICO PROSTÁTICO POR SOLO $1165.00 Promoción valida 31 de MARZO DEL 2026 O HASTA AGOTAR EXISTENCIAS.

CHECK UP MASCULINO PROMOCIÓN II
– QUÍMICA SANGUÍNEA DE 48 ELEMENTOS – BIOMETRÍA HEMÁTICA – EXAMEN GENERAL DE ORINA – ANTÍGENO ESPECÍFICO PROSTÁTICO POR SOLO $1390.00 Promoción valida 31 de MARZO DEL 2026 O HASTA AGOTAR EXISTENCIAS.

CHECK UP PROMOCIÓN III
– QUÍMICA SANGUÍNEA DE 48 ELEMENTOS – BIOMETRÍA HEMÁTICA – EXAMEN GENERAL DE ORINA POR SOLO $1170.00 Promoción valida 31 de MARZO DEL 2026 O HASTA AGOTAR EXISTENCIAS.

PROMOCIÓN GRUPO Y RH
PROMOCIÓN GRUPO SANGUÍNEO Y RH Por solo $50.00 Promoción valida HASTA AGOTAR EXISTENCIAS.

PERFIL DE PREVENCIÓN CARDÍACA
– Determinación NT-pro BNP – Colesterol de alta densidad HDL – Colesterol Total – Triglicéridos Por solo $1180.00 Promoción valida 31 de MARZO DEL 2026 O HASTA AGOTAR EXISTENCIAS.